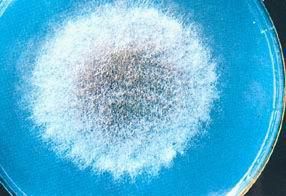
灰藍毛霉 灰藍毛霉

灰藍毛霉
| 拉丁綱名 | Phycomycetes |
| 中文綱名 | 藻狀菌綱 |
| 拉丁目名 | Mucorales |
| 中文目名 | 毛霉目 |
| 拉丁科名 | Mucoraceae |
| 中文科名 | 毛霉科 |
| 拉丁名 | Mucor griseo-cyanus |
| 中文名 | 灰藍毛霉 |
| 定名人 | Hagem |
| 參考文獻 | Mucoraceae |
灰藍毛霉,毛霉目,毛霉科,拉丁名是Mucor griseo-cyanus。
| 拉丁綱名 | Phycomycetes |
| 中文綱名 | 藻狀菌綱 |
| 拉丁目名 | Mucorales |
| 中文目名 | 毛霉目 |
| 拉丁科名 | Mucoraceae |
| 中文科名 | 毛霉科 |
| 拉丁名 | Mucor griseo-cyanus |
| 中文名 | 灰藍毛霉 |
| 定名人 | Hagem |
| 參考文獻 | Mucoraceae |
圖冊 孢子顏色有白、灰、黃、橙、紅、藍、綠等。在電子顯微鏡下觀察其表面...下來,當條件適宜時能萌發成菌絲體。毛霉屬中的總狀毛霉(M.rcemosus...,此後卵球生出外壁即成為卵孢子。②接合孢子:接合孢子是接合菌亞門、毛霉...
簡介 分類 特點 蕨類孢子普遍,在北京周口店龍骨山北坡的猿人洞穴中已經堆積了很厚的灰層,其中夾雜著...陶,基色灰紅,這是粘土經氧化焰焙燒後,其中三氧化二鐵呈紅色所造成的。陶料...。 黑陶 紅陶進一步發展為黑陶。黑陶色澤黑灰或烏黑,有的坯體中含有細石英砂...
中國古代化學史 正文 配圖 相關連線,此外麴黴屬的黑麴黴、灰綠麴黴、赭麴黴等,青黴屬的桔青黴、擴展青黴、指狀青黴等,毛霉,鐮孢霉,根霉,鏈黴菌等也能產生黃麴黴毒素。它們產生黃麴黴...
基本介紹 種類 特點 檢測試劑 毒性基本簡介黃麴黴素b1結構式黃麴黴素為分子真菌毒素。規定大米、食用油中黃麴黴毒素允許量標準為10ug/Kg,其他糧食、豆類及發酵食...
發現歷史 基本認識 化學結構 物質特點 檢測試劑極大。 (2)麴黴:主要有三種,黃麴黴、黑麴黴、灰麴黴。菌落形狀中間...。 (3)青黴與擬青黴:菌落顏色較青較藍,周圍白色,與食用菌爭奪養分和空間,危害性比麴黴大。 (4)毛霉、根霉:菌絲象爛棉絮,根霉會產生假根,是培...
灰白青黴 相關連線